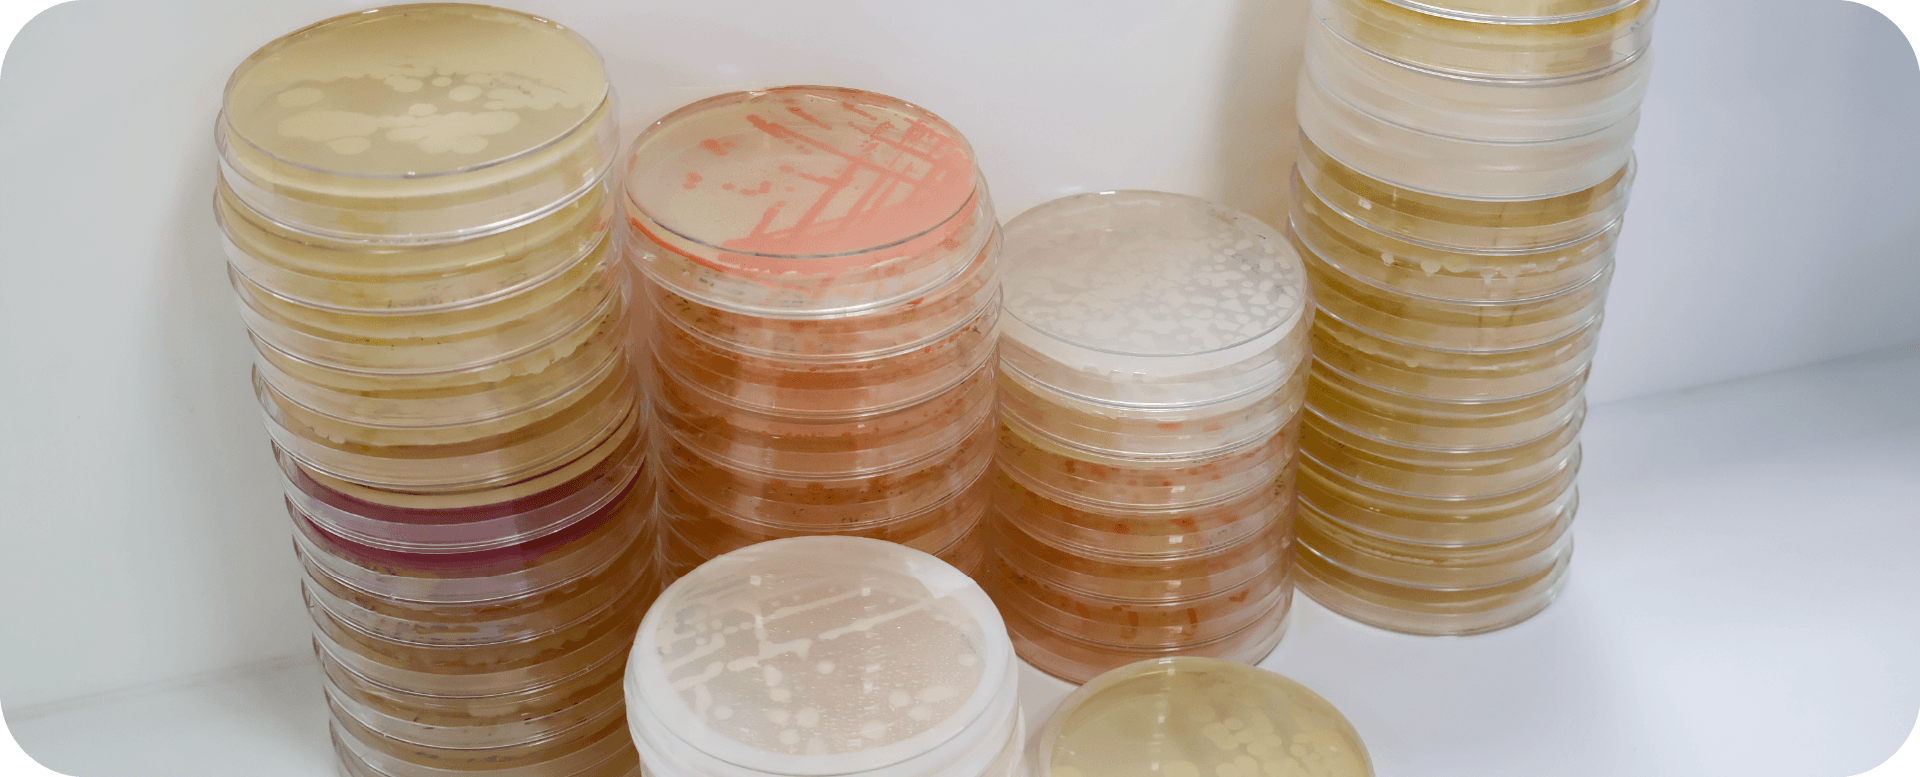
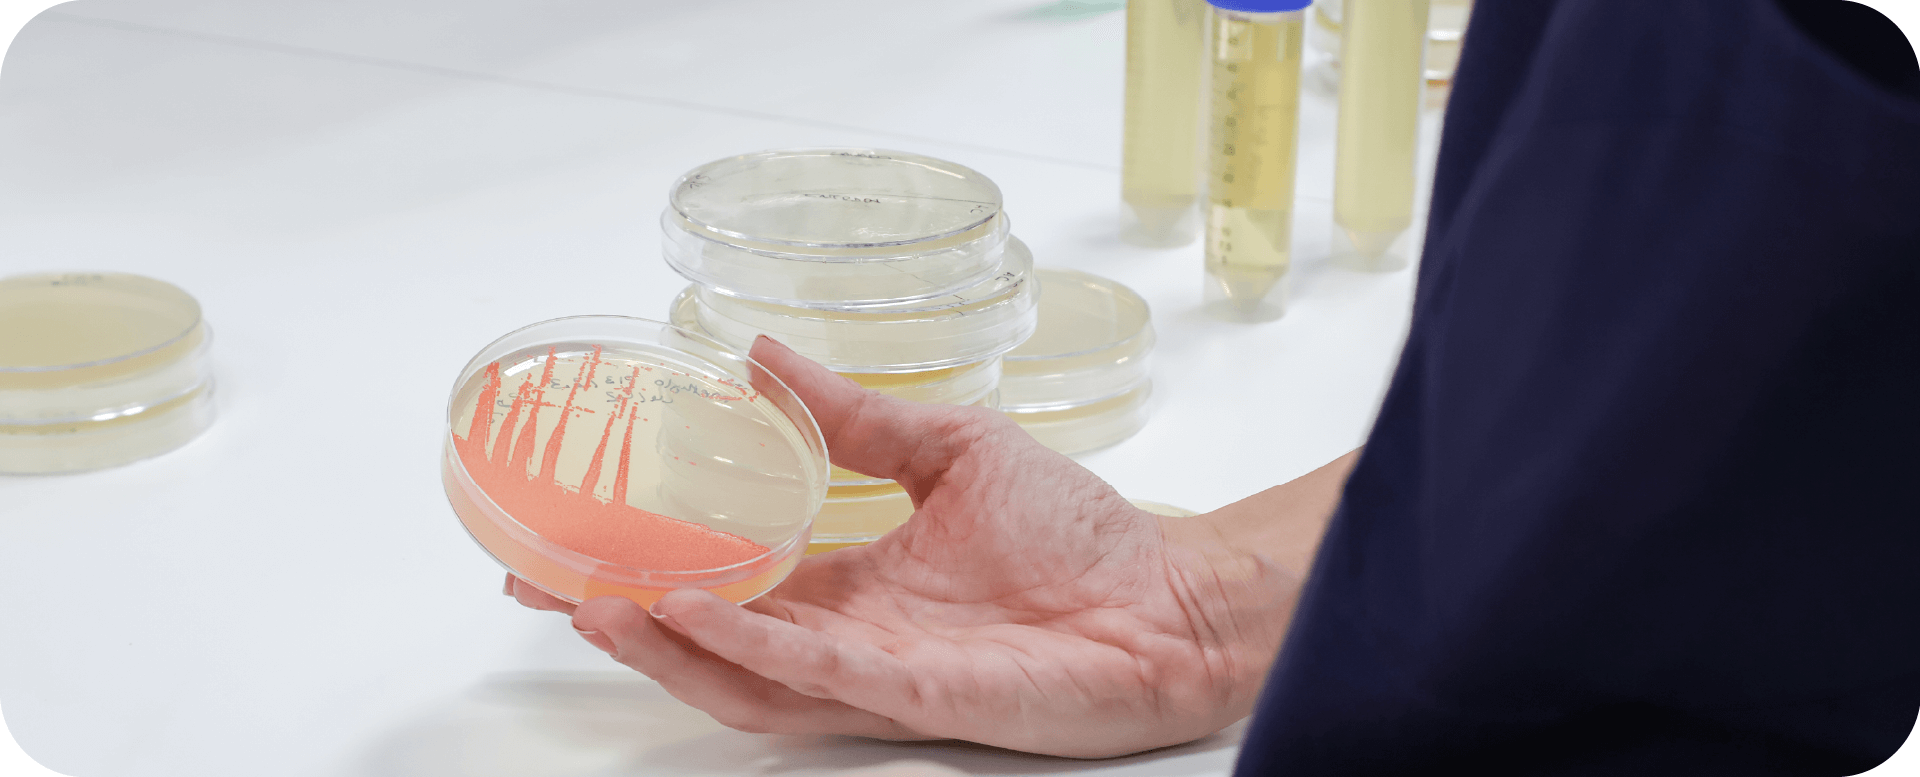

Descubre la mayor planta de biotecnología dedicada a la producción de microorganismos para la agricultura
Nosotros
Nuevas instalaciones
Las instalaciones de BIOLOGICA NATURE cuentan con 1.300 m² dedicados a la producción de insumos microbianos, con fermentadores de hasta 10.000L de capacidad.
La amplia experiencia de su equipo científico en el escalado de fermentaciones bacterianas, unida a la tecnología de vanguardia de su nueva planta, permite ofrecer un servicio integral de CMO y CDMO, que abarca desde el desarrollo hasta la fabricación de soluciones microbianas de alto valor añadido.
Nuestra planta dispone de todos los equipos necesarios para el desarrollo y la optimización de procesos de fermentación controlada, así como para las actividades de las etapas upstream / downstream.
300 m² de sala blanca
Más de 400 m² de sala blanca
Línea de envasado estéril
Reactores especializados
Almacén técnico
Soluciones que evolucionan contigo
Producción a medida
Desde la escala de laboratorio hasta la producción industrial, nuestros fermentadores permiten fabricar el volumen necesario para cubrir tus necesidades, garantizando en todo momento la calidad y la consistencia del proceso.
Preparado para el mercado
¿Necesitas tu producto en formato comercial? Contamos con equipos y líneas de envasado estéril que permiten entregar el producto directamente en su presentación final, listo para su distribución.
Tu socio de confianza
Gestionamos cada proyecto con la máxima confidencialidad y compromiso, como si fuera propio. Con más de 30 años de experiencia y un equipo altamente cualificado, trabajamos junto a ti para convertir tus objetivos en resultados reales.
Grupo De Sangosse
BIOLÓGICA NATURE es una empresa del Grupo DE SANGOSSE
El Grupo DE SANGOSSE es líder en el desarrollo de biosoluciones, y aspira a apoyar el ciclo productivo de forma sostenible con tecnología de vanguardia mediante la protección, la estimulación, la nutrición y la optimización y mejora de la vida del suelo.
Para lograrlo, el Grupo DE SANGOSSE integra un grupo de empresas expertas en cada área estratégica.
Biologica Nature,SLU es beneficiaria por Generalitat Valenciana, Conselleria de Industria, Turismo, Innovación y Comercio, de una subvención por importe de 10.872,06 € del programa dirigido a la reactivación económica en los municipios afectados por la DANA, dentro de la convocatoria de EMDANA 2025
Contacto
CONTACTA CON NOSOTROS
Estaremos encantados de ayudarte en el desarrollo y la fabricación de tus productos a base de microorganismos.
BIOLÓGICA NATURE
Calle Pinadeta, 26
46930 – Quart de Poblet
Valencia, España.
Tel: +34 961 640 032